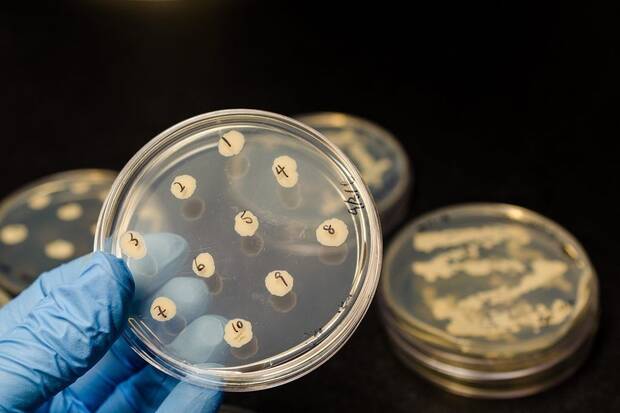
Bacterias resistentes

En silencio, sin titulares que inunden los medios, Estados Unidos enfrenta una crisis sanitaria que podría compararse con una epidemia: la propagación de las llamadas "bacterias pesadilla". Conocidas científicamente como Enterobacterales resistentes a carbapenémicos (CRE, por sus siglas en inglés), estos gérmenes presentan niveles de resistencia a los antibióticos que los expertos califican como "extremadamente preocupantes".
Alarma global por la “bacteria pesadilla”: los expertos advierten de su extrema resistencia
Los últimos datos de los Centros para el Control y la Prevención de Enfermedades (CDC) reflejan una escalada inquietante. Entre 2019 y 2023, las infecciones por CRE crecieron un 70%. El principal culpable es el gen NDM, un verdadero "escudo biológico" que anula la efectividad de los carbapenémicos, considerados medicamentos de último recurso frente a infecciones graves.
Hace apenas diez ańos, la presencia de NDM en Estados Unidos era marginal y asociada casi siempre a pacientes tratados en el extranjero. Hoy, la situación es otra: los casos se han multiplicado por cinco. En 2023, los CDC reportaron más de 4.300 infecciones por CRE, de las cuales 1.831 portaban el gen NDM. "El aumento de NDM es un grave peligro y muy preocupante", alertó David Weiss, especialista en enfermedades infecciosas de la Universidad de Emory, en declaraciones a Euro News.
El riesgo no se limita a las cifras. Muchos portadores podrían no presentar síntomas, facilitando la propagación silenciosa de estas bacterias en la comunidad. Incluso infecciones aparentemente rutinarias, como las urinarias, podrían derivar en cuadros crónicos y casi imposibles de tratar.
Un arsenal terapéutico cada vez más reducido
El tratamiento contra estas infecciones se ha vuelto extremadamente limitado. Solo dos antibióticos muestran eficacia, ambos administrados por vía intravenosa y a un coste elevado. "Estamos ante un escenario donde los tratamientos convencionales dejan de funcionar y los recursos efectivos son caros, escasos y difíciles de manejar", explican investigadores en Annals of Internal Medicine.
Los CRE se diseminan principalmente en hospitales y residencias de ancianos, propagándose a través de catéteres o tras cirugías, donde encuentran pacientes vulnerables y un uso intensivo de antibióticos. La pandemia de COVID-19 agravó la situación: el consumo masivo de antibióticos durante esos ańos podría haber impulsado la expansión de estas cepas resistentes, según Jason Burnham, de la Universidad de Washington.
La resistencia antimicrobiana ya figura entre las grandes amenazas globales para la salud pública en el siglo XXI, según la OMS. Aunque hoy el foco esté en Estados Unidos, la historia demuestra que los problemas de este calibre rara vez respetan fronteras, y lo que empieza como un brote local puede convertirse en un desafío sanitario internacional.
















